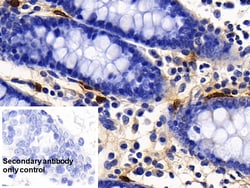
Invitrogen Tryptase Polyclonal Antibody, Invitrogen 200 &mu;L; Unconjugated:Antibodies,

missing translation for 'onlineSavingsMsg'
Learn More
Learn More
Invitrogen™ Tryptase Polyclonal Antibody, Invitrogen™


Rabbit Polyclonal Antibody
Brand: Invitrogen™ PA5145495
This item is not returnable.
View return policy
Description
Tryptase is a protein that belongs to the family of serine proteases and is primarily found in mast cells. It plays a crucial role in the immune response by cleaving and activating other proteins involved in inflammation and tissue repair. Tryptase is also involved in the regulation of blood pressure and has been implicated in various diseases, including asthma, allergies, and cardiovascular disorders. Its structure consists of four identical subunits that form a tetramer, and it is activated by proteolytic cleavage of its proenzyme form.
Specifications
| Tryptase | |
| Polyclonal | |
| Unconjugated | |
| MCT7 | |
| TPSG1/TPSB2/TPSAB1/TPSD1 | |
| Rabbit | |
| Antigen affinity chromatography, Protein A | |
| RUO | |
| 397389 | |
| Store at 4°C short term. For long term storage, store at -20°C, avoiding freeze/thaw cycles. | |
| Liquid |
| Immunohistochemistry (Paraffin), Western Blot | |
| 0.5 mg/mL | |
| PBS with 50% glycerol and 0.05% Proclin 300; pH 7.4 | |
| Q9N2D1 | |
| MCT7 | |
| Recombinant Pig TPS protein, Ile31-Ser275 (Accession #Q9N2D1). | |
| 200 μL | |
| Primary | |
| Pig | |
| Antibody | |
| IgG |
Product Content Correction
Your input is important to us. Please complete this form to provide feedback related to the content on this product.
Product Title
Spot an opportunity for improvement?Share a Content Correction